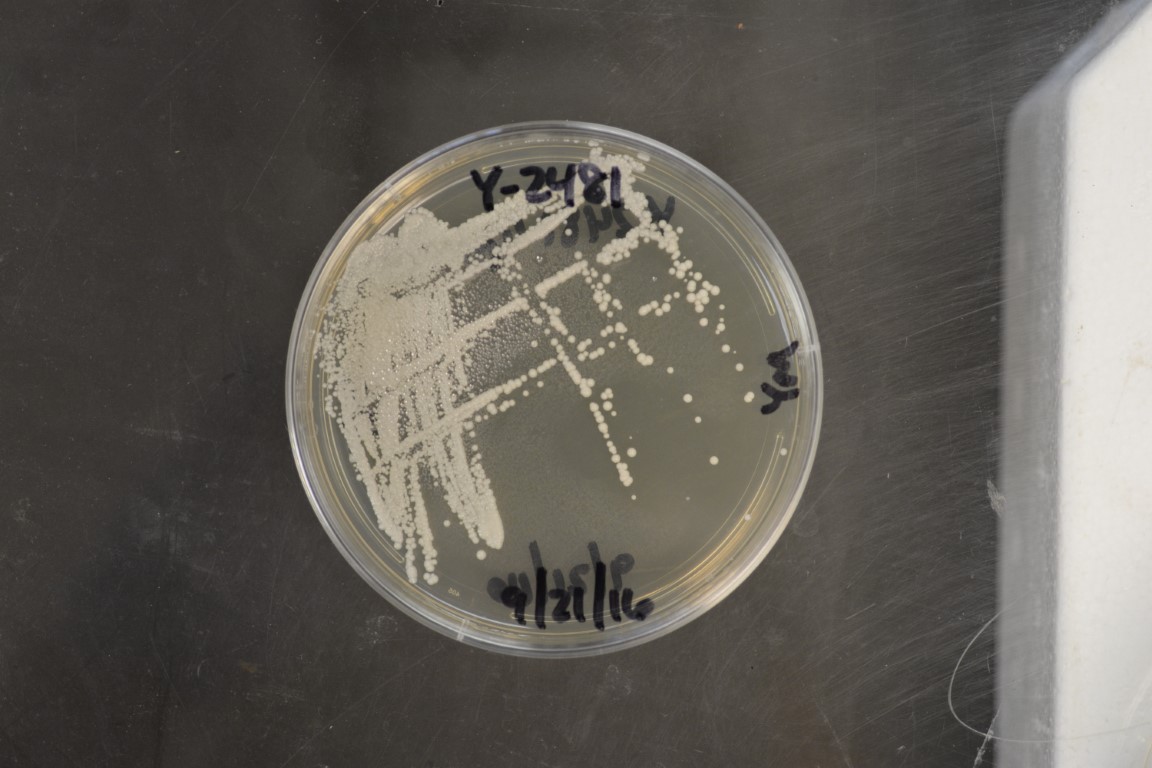

Candida apicola
NRRL Y-2481(Type Strain)
Accession numbers in other collections:ATCC 24616=CBS 2868=CCRC 22277=CCY 26-29-1=IFO 10261=IGC 3525=JCM 9592=NRIC 1802=VKM Y-1533=VKM Y-1670
Source:CBS,Delft,The Netherlands
Isolated from(substrate):IN,bee's gut
Substrate location:Croatia
Genetic info:Robnett PCR#102.GenBank:D1/D2(U45703),ITS/D1/D2(EU926482).
Growth media:Yeast Extract-Malt Extract-Peptone-Glucose(YM for yeasts)(number 6)
Optimum growth temperature:25C
Strain images:
NRRL_Y-2481_6.JPG

Comments:Antonie van Leeuwenhoek(2010)97:155-170.